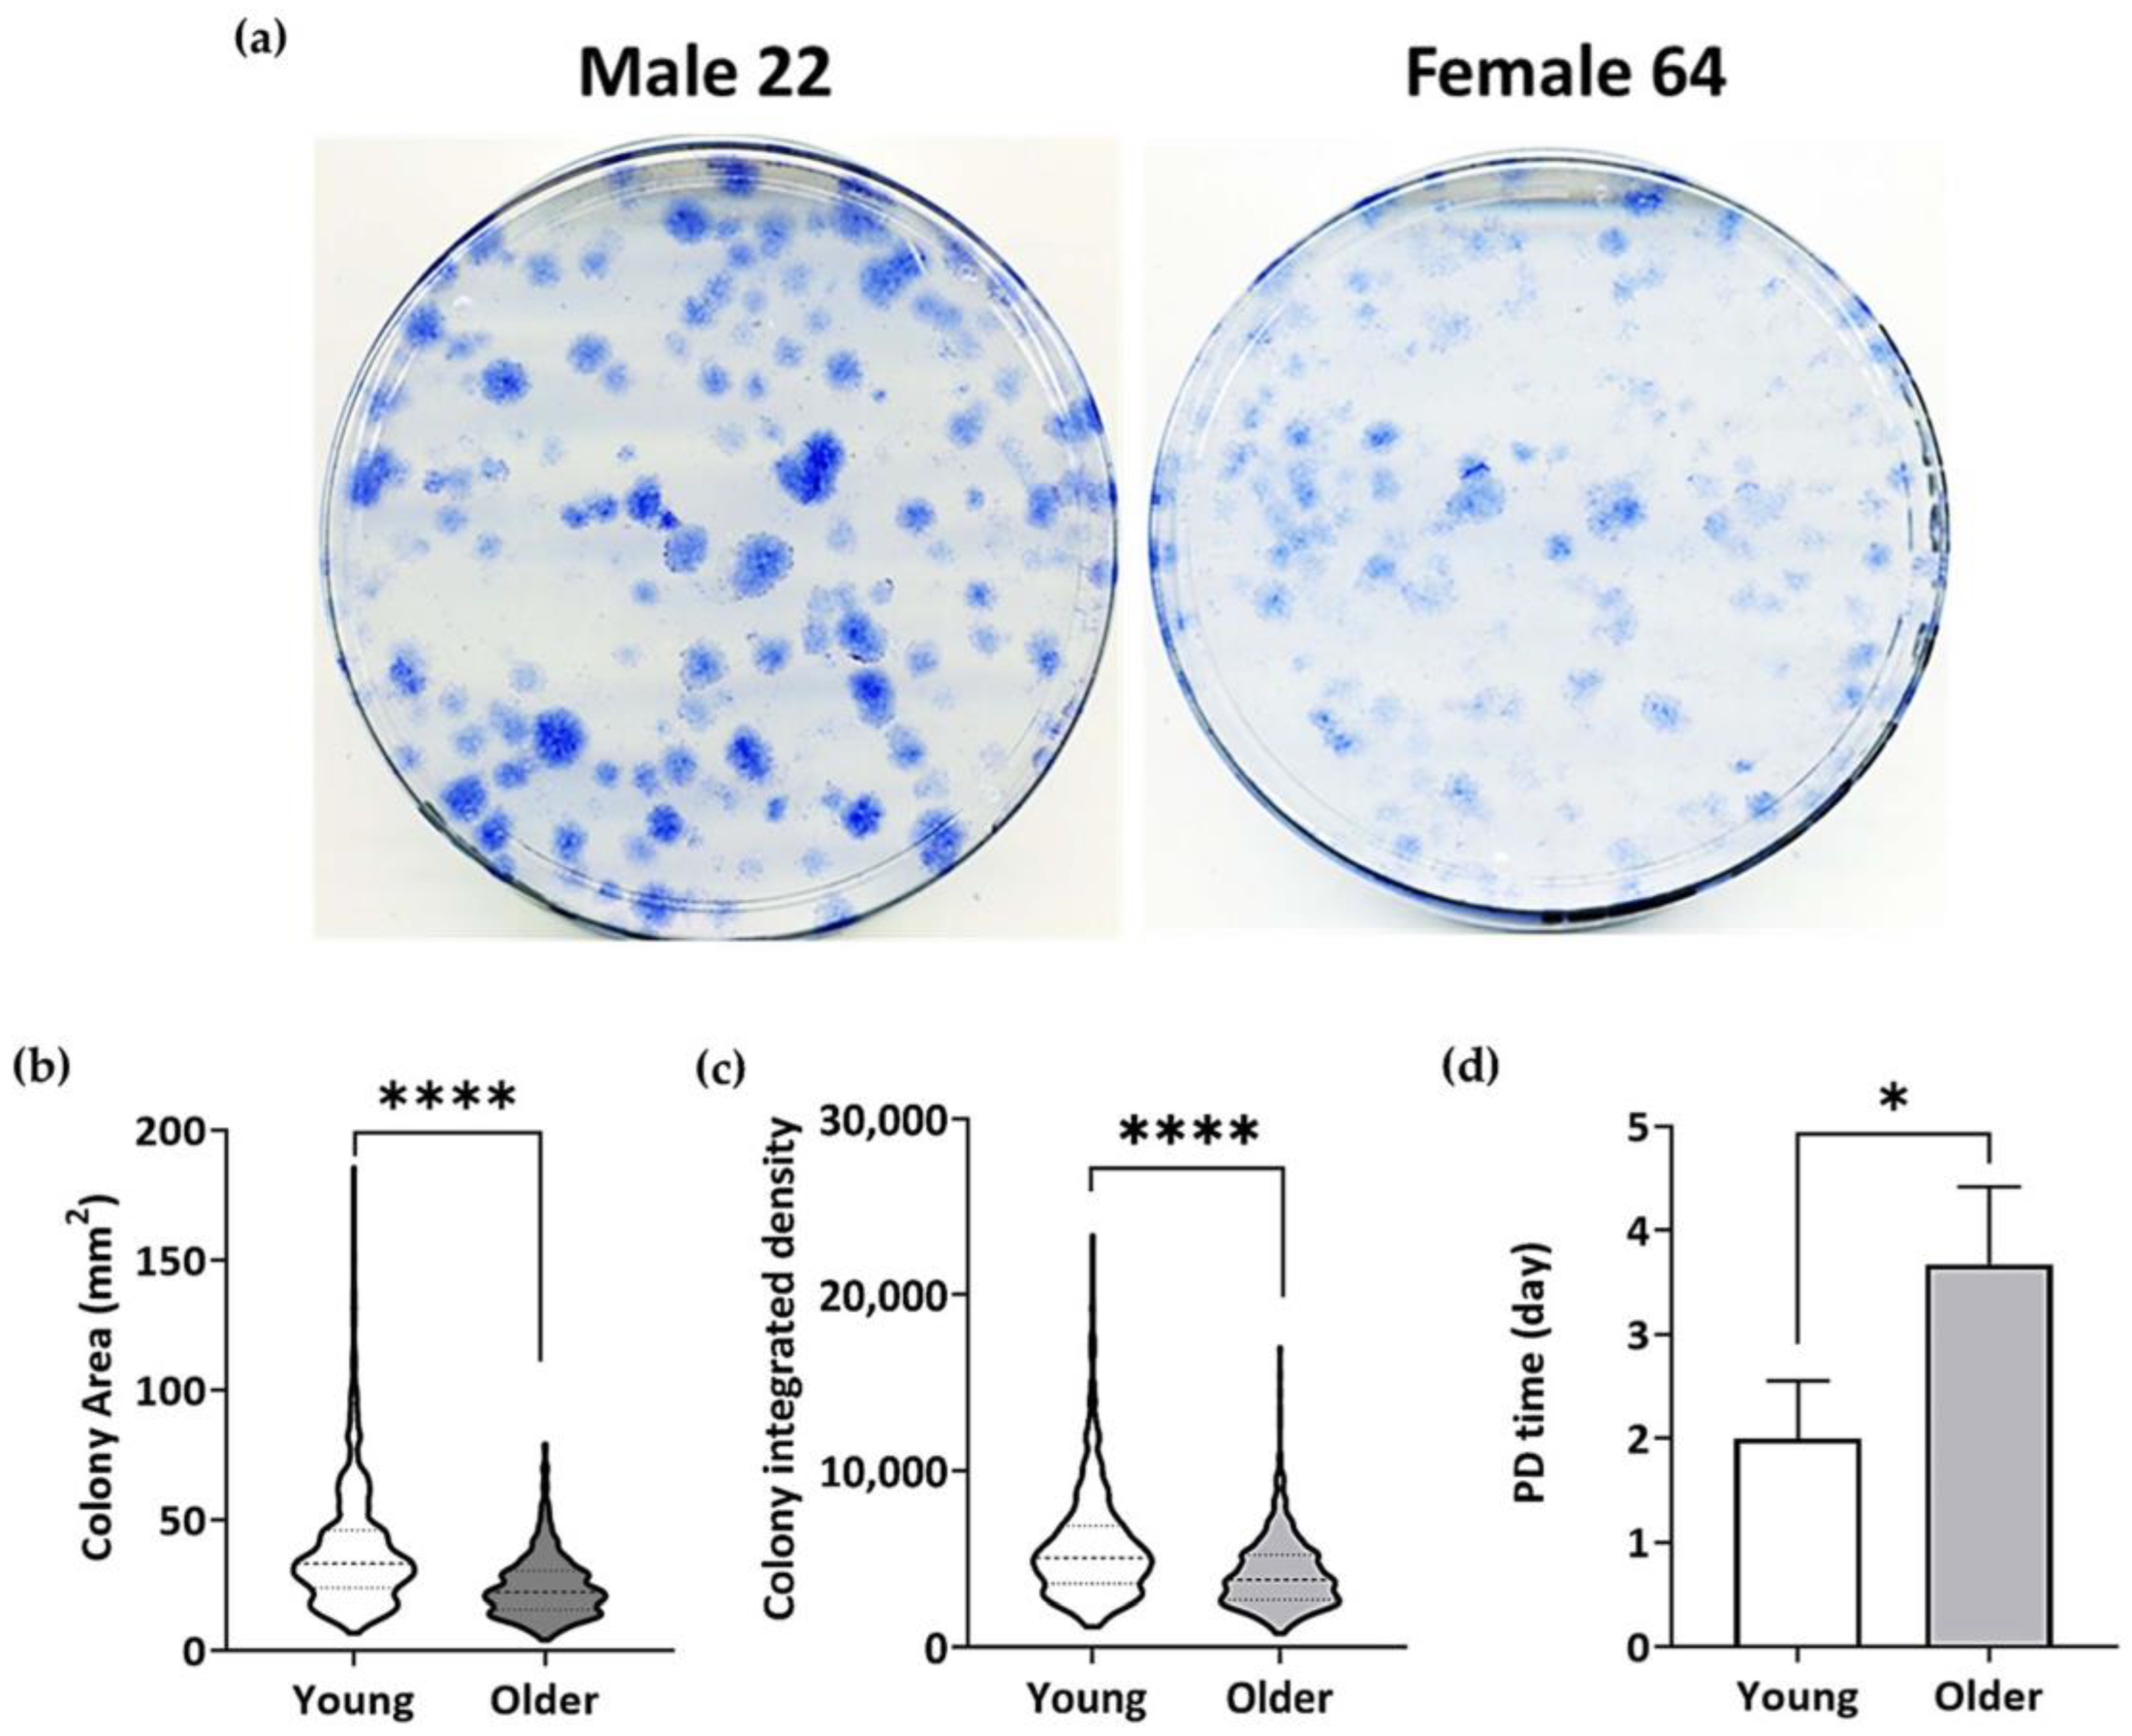
Bioengineering 11 00143 g003

In Vitro Osteogenesis Study of Shell Nacre Cement with Older and Young Donor Bone Marrow Mesenchymal Stem/Stromal Cells
Abstract
1. Introduction
2. Materials and Methods
2.1. Shell Nacre Cement (SNC) Samples
2.2. Ethical Approval and Donor Details
2.3. Direct Cytotoxicity Studies
2.4. Indirect Cytotoxicity Studies—XTT Assay
2.4.1. Cell Viability (24 h Exposure)
2.4.2. Cell Proliferation (4 Days Exposure)
2.5. Characterization of Older and Young Donor BM-MSCs
2.5.1. Calculation of Population Doubling Time Assay
2.5.2. Colony-Forming Unit-Fibroblast (CFU-F) Assay
2.6. Studies with Pooled Older and Young Donor BM-MSCs
2.6.1. Cell Morphology
2.6.2. Senescence-Associated Beta-Galactosidase (SA-β-Gal) Assay
2.6.3. Confocal Microscopy of BM-MSC Attachment and Proliferation on SNC
2.6.4. In Vitro Osteogenic Potential of BM-MSCs Cultured on SNC
2.6.5. Gene Expression
2.7. Statistical Analysis
3. Results
3.1. Non-Cytotoxic Nature of SNC with BM-MSCs
3.2. Lower Proliferation Capacity and Higher PD Time of Older Donor BM-MSCs
3.3. BM-MSCs of Older Donors Exhibited Senescent Features
3.4. Viability and Proliferation of Young and Older Donor BM-MSCs on SNC
3.5. In Vitro Osteogenic Potential of SNC
3.6. Gene Expression Studies
4. Discussion
Supplementary Materials
Author Contributions
Funding
Institutional Review Board Statement
Informed Consent Statement
Data Availability Statement
Acknowledgments
Conflicts of Interest
References
- Al-Bari, A.A.; Al Mamun, A. Current Advances in Regulation of Bone Homeostasis. FASEB Bioadv. 2020, 2, 668–679. [Google Scholar] [CrossRef]
- Datta, H.K.; Ng, W.F.; Walker, J.A.; Tuck, S.P.; Varanasi, S.S. The Cell Biology of Bone Metabolism. J. Clin. Pathol. 2008, 61, 577–587. [Google Scholar] [CrossRef]
- Jones, E.; McGonagle, D. Human Bone Marrow Mesenchymal Stem Cells in Vivo. Rheumatology 2008, 47, 126–131. [Google Scholar] [CrossRef]
- Jones, E.; Yang, X. Mesenchymal Stem Cells and Bone Regeneration: Current Status. Injury 2011, 42, 562–568. [Google Scholar] [CrossRef]
- Pittenger, M.F.; Discher, D.E.; Péault, B.M.; Phinney, D.G.; Hare, J.M.; Caplan, A.I. Mesenchymal Stem Cell Perspective: Cell Biology to Clinical Progress. Npj Regen. Med. 2019, 4, 22. [Google Scholar] [CrossRef] [PubMed]
- Bielby, R.; Jones, E.; McGonagle, D. The Role of Mesenchymal Stem Cells in Maintenance and Repair of Bone. Injury 2007, 38, S26–S32. [Google Scholar] [CrossRef]
- Wang, X.; Wang, Y.; Gou, W.; Lu, Q.; Peng, J.; Lu, S. Role of Mesenchymal Stem Cells in Bone Regeneration and Fracture Repair: A Review. Int. Orthop. 2013, 37, 2491–2498. [Google Scholar] [CrossRef]
- Shah, S.; Ghosh, D.; Otsuka, T.; Laurencin, C.T. Classes of Stem Cells: From Biology to Engineering. Regen. Eng. Transl. Med. 2023. [Google Scholar] [CrossRef]
- Clarke, B.L.; Khosla, S. Physiology of Bone Loss. Radiol. Clin. 2010, 48, 483–495. [Google Scholar] [CrossRef] [PubMed]
- Rolvien, T.; Amling, M. Bone Biology in the Elderly: Clinical Importance for Fracture Treatment. Innov. Surg. Sci. 2016, 1, 49–55. [Google Scholar] [CrossRef]
- Ganguly, P.; El-Jawhari, J.J.; Burska, A.N.; Ponchel, F.; Giannoudis, P.V.; Jones, E.A. The Analysis of In Vivo ageing in Human Bone Marrow Mesenchymal Stromal Cells Using Colony-Forming Unit-Fibroblast Assay and the CD45lowCD271+ Phenotype. Stem Cells Int. 2019, 2019, e5197983. [Google Scholar] [CrossRef]
- Chen, Q.; Shou, P.; Zheng, C.; Jiang, M.; Cao, G.; Yang, Q.; Cao, J.; Xie, N.; Velletri, T.; Zhang, X.; et al. Fate Decision of Mesenchymal Stem Cells: Adipocytes or Osteoblasts? Cell Death Differ. 2016, 23, 1128–1139. [Google Scholar] [CrossRef]
- Pignolo, R.J.; Samsonraj, R.M.; Law, S.F.; Wang, H.; Chandra, A. Targeting Cell Senescence for the Treatment of Age-Related Bone Loss. Curr. Osteoporos. Rep. 2019, 17, 70–85. [Google Scholar] [CrossRef] [PubMed]
- Meunier, P.; Aaron, J.; Edouard, C.; Vlgnon, G. Osteoporosis and the Replacement of Cell Populations of the Marrow by Adipose Tissue: A Quantitative Study of 84 Iliac Bone Biopsies. Clin. Orthop. Relat. Res. 1971, 80, 147. [Google Scholar] [CrossRef]
- Justesen, J.; Stenderup, K.; Ebbesen, E.N.; Mosekilde, L.; Steiniche, T.; Kassem, M. Adipocyte Tissue Volume in Bone Marrow Is Increased with Aging and in Patients with Osteoporosis. Biogerontology 2001, 2, 165–171. [Google Scholar] [CrossRef]
- Rodríguez, J.P.; Montecinos, L.; Ríos, S.; Reyes, P.; Martínez, J. Mesenchymal Stem Cells from Osteoporotic Patients Produce a Type I Collagen-Deficient Extracellular Matrix Favoring Adipogenic Differentiation. J. Cell Biochem. 2000, 79, 557–565. [Google Scholar] [CrossRef]
- Nuttall, M.E.; Patton, A.J.; Olivera, D.L.; Nadeau, D.P.; Gowen, M. Human Trabecular Bone Cells Are Able to Express Both Osteoblastic and Adipocytic Phenotype: Implications for Osteopenic Disorders. J. Bone Miner. Res. 1998, 13, 371–382. [Google Scholar] [CrossRef] [PubMed]
- Singh, L.; Brennan, T.A.; Russell, E.; Kim, J.-H.; Chen, Q.; Brad Johnson, F.; Pignolo, R.J. Aging Alters Bone-Fat Reciprocity by Shifting in Vivo Mesenchymal Precursor Cell Fate towards an Adipogenic Lineage. Bone 2016, 85, 29–36. [Google Scholar] [CrossRef]
- Wang, C.; Meng, H.; Wang, X.; Zhao, C.; Peng, J.; Wang, Y. Differentiation of Bone Marrow Mesenchymal Stem Cells in Osteoblasts and Adipocytes and Its Role in Treatment of Osteoporosis. Med. Sci. Monit. 2016, 22, 226–233. [Google Scholar] [CrossRef]
- Zhou, S.; Greenberger, J.S.; Epperly, M.W.; Goff, J.P.; Adler, C.; LeBoff, M.S.; Glowacki, J. Age-Related Intrinsic Changes in Human Bone-Marrow-Derived Mesenchymal Stem Cells and Their Differentiation to Osteoblasts. Aging Cell 2008, 7, 335–343. [Google Scholar] [CrossRef]
- Johnell, O.; Kanis, J.A. An Estimate of the Worldwide Prevalence and Disability Associated with Osteoporotic Fractures. Osteoporos. Int. 2006, 17, 1726–1733. [Google Scholar] [CrossRef]
- Wu, A.-M.; Bisignano, C.; James, S.L.; Abady, G.G.; Abedi, A.; Abu-Gharbieh, E.; Alhassan, R.K.; Alipour, V.; Arabloo, J.; Asaad, M.; et al. Global, Regional, and National Burden of Bone Fractures in 204 Countries and Territories, 1990–2019: A Systematic Analysis from the Global Burden of Disease Study 2019. Lancet Healthy Longev. 2021, 2, e580–e592. [Google Scholar] [CrossRef]
- Moore, W.R.; Graves, S.E.; Bain, G.I. Synthetic Bone Graft Substitutes. ANZ J. Surg. 2001, 71, 354–361. [Google Scholar] [CrossRef] [PubMed]
- Giannoudis, P.V.; Dinopoulos, H.; Tsiridis, E. Bone Substitutes: An Update. Injury 2005, 36 (Suppl. 3), S20–S27. [Google Scholar] [CrossRef]
- Fernandez de Grado, G.; Keller, L.; Idoux-Gillet, Y.; Wagner, Q.; Musset, A.-M.; Benkirane-Jessel, N.; Bornert, F.; Offner, D. Bone Substitutes: A Review of Their Characteristics, Clinical Use, and Perspectives for Large Bone Defects Management. J. Tissue Eng. 2018, 9, 2041731418776819. [Google Scholar] [CrossRef]
- Brown, J.L.; Laurencin, C.T. 2.6.6—Bone Tissue Engineering. In Biomaterials Science, 4th ed.; Wagner, W.R., Sakiyama-Elbert, S.E., Zhang, G., Yaszemski, M.J., Eds.; Academic Press: Cambridge, MA, USA, 2020; pp. 1373–1388. ISBN 978-0-12-816137-1. [Google Scholar]
- Wickramasinghe, M.L.; Dias, G.J.; Premadasa, K.M.G.P. A Novel Classification of Bone Graft Materials. J. Biomed. Mater. Res. Part B Appl. Biomater. 2022, 110, 1724–1749. [Google Scholar] [CrossRef]
- Piccirilli, E.; Cariati, I.; Primavera, M.; Triolo, R.; Gasbarra, E.; Tarantino, U. Augmentation in Fragility Fractures, Bone of Contention: A Systematic Review. BMC Musculoskelet. Disord. 2022, 23, 1046. [Google Scholar] [CrossRef]
- He, Z.; Zhai, Q.; Hu, M.; Cao, C.; Wang, J.; Yang, H.; Li, B. Bone Cements for Percutaneous Vertebroplasty and Balloon Kyphoplasty: Current Status and Future Developments. J. Orthop. Transl. 2015, 3, 1–11. [Google Scholar] [CrossRef] [PubMed]
- Hasandoost, L.; Rodriguez, O.; Alhalawani, A.; Zalzal, P.; Schemitsch, E.H.; Waldman, S.D.; Papini, M.; Towler, M.R. The Role of Poly(Methyl Methacrylate) in Management of Bone Loss and Infection in Revision Total Knee Arthroplasty: A Review. J. Funct. Biomater. 2020, 11, 25. [Google Scholar] [CrossRef] [PubMed]
- Mancuso, F.; Beltrame, A.; Colombo, E.; Miani, E.; Bassini, F. Management of Metaphyseal Bone Loss in Revision Knee Arthroplasty. Acta Biomed. 2017, 88, 98–111. [Google Scholar] [CrossRef] [PubMed]
- Beckmann, N.A.; Mueller, S.; Gondan, M.; Jaeger, S.; Reiner, T.; Bitsch, R.G. Treatment of Severe Bone Defects during Revision Total Knee Arthroplasty with Structural Allografts and Porous Metal Cones—A Systematic Review. J. Arthroplast. 2015, 30, 249–253. [Google Scholar] [CrossRef]
- Reito, A.; Ylitalo, A. Polymethyl Methacrylate Cement Fill as a Definitive Treatment for Massive Bone Defect after Infected Internal Fixation in Bicondylar Tibial Fracture: A Case Report. JBJS Case Connector. 2020, 10, e19.00286. [Google Scholar] [CrossRef]
- Wu, M.; Yao, S.; Xie, Y.; Yan, F.; Deng, Z.; Lei, J.; Cai, L. A Novel Subchondral Bone-Grafting Procedure for the Treatment of Giant-Cell Tumor around the Knee: A Retrospective Study of 27 Cases. Medicine 2018, 97, e13154. [Google Scholar] [CrossRef]
- Vaishya, R.; Chauhan, M.; Vaish, A. Bone Cement. J. Clin. Orthop. Trauma 2013, 4, 157–163. [Google Scholar] [CrossRef]
- O’dowd-Booth, C.J.; White, J.; Smitham, P.; Khan, W.; Marsh, D.R. Bone Cement: Perioperative Issues, Orthopaedic Applications and Future Developments. J. Perioper. Pract. 2011, 21, 304–308. [Google Scholar] [CrossRef] [PubMed]
- Soleymani Eil Bakhtiari, S.; Bakhsheshi-Rad, H.R.; Karbasi, S.; Tavakoli, M.; Razzaghi, M.; Ismail, A.F.; RamaKrishna, S.; Berto, F. Polymethyl Methacrylate-Based Bone Cements Containing Carbon Nanotubes and Graphene Oxide: An Overview of Physical, Mechanical, and Biological Properties. Polymers 2020, 12, 1469. [Google Scholar] [CrossRef] [PubMed]
- Nandi, S.K.; Roy, S.; Mukherjee, P.; Kundu, B.; De, D.K.; Basu, D. Orthopaedic Applications of Bone Graft & Graft Substitutes: A Review. Indian J. Med. Res. 2010, 132, 15. [Google Scholar] [PubMed]
- Lopez, E.; Vidal, B.; Berland, S.; Camprasse, S.; Camprasse, G.; Silve, C. Demonstration of the Capacity of Nacre to Induce Bone Formation by Human Osteoblasts Maintained in Vitro. Tissue Cell 1992, 24, 667–679. [Google Scholar] [CrossRef]
- Kim, H.; Lee, K.; Ko, C.-Y.; Kim, H.-S.; Shin, H.-I.; Kim, T.; Lee, S.H.; Jeong, D. The Role of Nacreous Factors in Preventing Osteoporotic Bone Loss through Both Osteoblast Activation and Osteoclast Inactivation. Biomaterials 2012, 33, 7489–7496. [Google Scholar] [CrossRef]
- Lee, K.; Kim, H.; Kim, J.M.; Chung, Y.H.; Lee, T.Y.; Lim, H.-S.; Lim, J.-H.; Kim, T.; Bae, J.S.; Woo, C.-H.; et al. Nacre-Driven Water-Soluble Factors Promote Wound Healing of the Deep Burn Porcine Skin by Recovering Angiogenesis and Fibroblast Function. Mol. Biol. Rep. 2012, 39, 3211–3218. [Google Scholar] [CrossRef]
- Lizymol, P.P. Studies on Shrinkage, Depth of Cure, and Cytotoxic Behavior of Novel Organically Modified Ceramic Based Dental Restorative Resins. J. Appl. Polym. Sci. 2010, 116, 2645–2650. [Google Scholar] [CrossRef]
- Bridget Jeyatha, W.; Paul, W.; Mani, S.; Lizymol, P.P. Synthesis and Characterization of Ladder Structured Ormocer Resin of Siloxane Backbone and Methacrylate Side Chain. Mater. Lett. 2022, 310, 131192. [Google Scholar] [CrossRef]
- Wilson, B.J.; Philipose Pampadykandathil, L. Novel Bone Void Filling Cement Compositions Based on Shell Nacre and Siloxane Methacrylate Resin: Development and Characterization. Bioengineering 2023, 10, 752. [Google Scholar] [CrossRef]
- Stolzing, A.; Jones, E.; McGonagle, D.; Scutt, A. Age-Related Changes in Human Bone Marrow-Derived Mesenchymal Stem Cells: Consequences for Cell Therapies. Mech. Ageing Dev. 2008, 129, 163–173. [Google Scholar] [CrossRef]
- Quatman, C.E.; Wiseman, J.; Phieffer, L. Academic Geriatric Orthopaedics: A New Paradigm for Inpatient Care. Curr. Geriatr. Rep. 2018, 7, 272–277. [Google Scholar] [CrossRef]
- Ganguly, P.; El-Jawhari, J.J.; Vun, J.; Giannoudis, P.V.; Jones, E.A. Evaluation of Human Bone Marrow Mesenchymal Stromal Cell (MSC) Functions on a Biomorphic Rattan-Wood-Derived Scaffold: A Comparison between Cultured and Uncultured MSCs. Bioengineering 2022, 9, 1. [Google Scholar] [CrossRef]
- Li, W.-J.; Tuli, R.; Huang, X.; Laquerriere, P.; Tuan, R.S. Multilineage Differentiation of Human Mesenchymal Stem Cells in a Three-Dimensional Nanofibrous Scaffold. Biomaterials 2005, 26, 5158–5166. [Google Scholar] [CrossRef] [PubMed]
- Li, Z.; Xiang, S.; Lin, Z.; Li, E.N.; Yagi, H.; Cao, G.; Yocum, L.; Li, L.; Hao, T.; Bruce, K.K.; et al. Graphene Oxide-Functionalized Nanocomposites Promote Osteogenesis of Human Mesenchymal Stem Cells via Enhancement of BMP-SMAD1/5 Signaling Pathway. Biomaterials 2021, 277, 121082. [Google Scholar] [CrossRef]
- Ganguly, P. Bone-Resident Mesenchymal Stromal Cells in Healthy Ageing and Osteoarthritis: Enumeration and Gene Expression Analysis in Uncultured Cells. Ph.D. Thesis, University of Leeds, Leeds, UK, 2019. [Google Scholar]
- Owston, H.E.; Ganguly, P.; Tronci, G.; Russell, S.J.; Giannoudis, P.V.; Jones, E.A. Colony Formation, Migratory, and Differentiation Characteristics of Multipotential Stromal Cells (MSCs) from “Clinically Accessible” Human Periosteum Compared to Donor-Matched Bone Marrow MSCs. Stem Cells Int. 2019, 2019, e6074245. [Google Scholar] [CrossRef]
- ISO 10993-12:2021(En); Biological Evaluation of Medical Devices—Part 12: Sample Preparation and Reference Materials. The International Organization for standardization: Geneva, Switzerland, 2021. Available online: https://www.iso.org/obp/ui/#iso:std:iso:10993:-12:ed-5:v1:en (accessed on 17 March 2023).
- Ganguly, P.; Fiz, N.; Beitia, M.; Owston, H.E.; Delgado, D.; Jones, E.; Sánchez, M. Effect of Combined Intraosseous and Intraarticular Infiltrations of Autologous Platelet-Rich Plasma on Subchondral Bone Marrow Mesenchymal Stromal Cells from Patients with Hip Osteoarthritis. J. Clin. Med. 2022, 11, 3891. [Google Scholar] [CrossRef]
- El-Jawhari, J.J.; Cuthbert, R.; McGonagle, D.; Jones, E.; Giannoudis, P.V. The CD45lowCD271high Cell Prevalence in Bone Marrow Samples May Provide a Useful Measurement of the Bone Marrow Quality for Cartilage and Bone Regenerative Therapy. J. Bone Joint. Surg. Am. 2017, 99, 1305–1313. [Google Scholar] [CrossRef]
- Kouroupis, D.; Baboolal, T.G.; Jones, E.; Giannoudis, P.V. Native Multipotential Stromal Cell Colonization and Graft Expander Potential of a Bovine Natural Bone Scaffold. J. Orthop. Res. 2013, 31, 1950–1958. [Google Scholar] [CrossRef] [PubMed]
- Sanjurjo-Rodriguez, C.; Altaie, A.; Mastbergen, S.; Baboolal, T.; Welting, T.; Lafeber, F.; Pandit, H.; McGonagle, D.; Jones, E. Gene Expression Signatures of Synovial Fluid Multipotent Stromal Cells in Advanced Knee Osteoarthritis and Following Knee Joint Distraction. Front. Bioeng. Biotechnol. 2020, 8, 579751. [Google Scholar] [CrossRef]
- Fragkakis, E.M.; El-Jawhari, J.J.; Dunsmuir, R.A.; Millner, P.A.; Rao, A.S.; Henshaw, K.T.; Pountos, I.; Jones, E.; Giannoudis, P.V. Vertebral Body versus Iliac Crest Bone Marrow as a Source of Multipotential Stromal Cells: Comparison of Processing Techniques, Tri-Lineage Differentiation and Application on a Scaffold for Spine Fusion. PLoS ONE 2018, 13, e0197969. [Google Scholar] [CrossRef]
- Ruan, R.; Zheng, M.; Gao, J.; Landao-Bassonga, E.; Chen, L.; Chen, P.; Wang, T.; Zhao, X. Improved Biological Properties of Calcium Phosphate Cement by Nacre Incorporation: An In Vitro Study. J. Biomater. Tissue Eng. 2018, 8, 67–79. [Google Scholar] [CrossRef]
- Breeland, G.; Sinkler, M.A.; Menezes, R.G. Embryology, Bone Ossification. In StatPearls; StatPearls Publishing: Treasure Island, FL, USA, 2023. [Google Scholar]
- Corrado, A.; Cici, D.; Rotondo, C.; Maruotti, N.; Cantatore, F.P. Molecular Basis of Bone Aging. Int. J. Mol. Sci. 2020, 21, 3679. [Google Scholar] [CrossRef]
- Churchman, S.M.; Boxall, S.A.; McGonagle, D.; Jones, E.A. Predicting the Remaining Lifespan and Cultivation-Related Loss of Osteogenic Capacity of Bone Marrow Multipotential Stromal Cells Applicable across a Broad Donor Age Range. Stem Cells Int. 2017, 2017, 6129596. [Google Scholar] [CrossRef]
- El-Jawhari, J.J.; Ganguly, P.; Jones, E.; Giannoudis, P.V. Bone Marrow Multipotent Mesenchymal Stromal Cells as Autologous Therapy for Osteonecrosis: Effects of Age and Underlying Causes. Bioengineering 2021, 8, 69. [Google Scholar] [CrossRef] [PubMed]
- Siegel, G.; Kluba, T.; Hermanutz-Klein, U.; Bieback, K.; Northoff, H.; Schäfer, R. Phenotype, Donor Age and Gender Affect Function of Human Bone Marrow-Derived Mesenchymal Stromal Cells. BMC Med. 2013, 11, 146. [Google Scholar] [CrossRef] [PubMed]
- Vogt, A.; Kapetanos, K.; Christodoulou, N.; Asimakopoulos, D.; Birch, M.A.; McCaskie, A.W.; Khan, W. The Effects of Chronological Age on the Chondrogenic Potential of Mesenchymal Stromal Cells: A Systematic Review. Int. J. Mol. Sci. 2023, 24, 15494. [Google Scholar] [CrossRef]
- Zhai, W.; Tan, J.; Russell, T.; Chen, S.; McGonagle, D.; Win Naing, M.; Yong, D.; Jones, E. Multi-Pronged Approach to Human Mesenchymal Stromal Cells Senescence Quantification with a Focus on Label-Free Methods. Sci. Rep. 2021, 11, 1054. [Google Scholar] [CrossRef]
- Carvalho, M.S.; Alves, L.; Bogalho, I.; Cabral, J.M.S.; da Silva, C.L. Impact of Donor Age on the Osteogenic Supportive Capacity of Mesenchymal Stromal Cell-Derived Extracellular Matrix. Front. Cell Dev. Biol. 2021, 9, 747521. [Google Scholar] [CrossRef]
- Asumda, F.Z.; Chase, P.B. Age-Related Changes in Rat Bone-Marrow Mesenchymal Stem Cell Plasticity. BMC Cell Biol. 2011, 12, 44. [Google Scholar] [CrossRef]
- Debacq-Chainiaux, F.; Erusalimsky, J.D.; Campisi, J.; Toussaint, O. Protocols to Detect Senescence-Associated Beta-Galactosidase (SA-Βgal) Activity, a Biomarker of Senescent Cells in Culture and in Vivo. Nat. Protoc. 2009, 4, 1798–1806. [Google Scholar] [CrossRef]
- Liu, J.; Ding, Y.; Liu, Z.; Liang, X. Senescence in Mesenchymal Stem Cells: Functional Alterations, Molecular Mechanisms, and Rejuvenation Strategies. Front. Cell Dev. Biol. 2020, 8, 258. [Google Scholar] [CrossRef]
- Safwan-Zaiter, H.; Wagner, N.; Wagner, K.-D. P16INK4A—More Than a Senescence Marker. Life 2022, 12, 1332. [Google Scholar] [CrossRef] [PubMed]
- Farr, J.N.; Khosla, S. Cellular Senescence in Bone. Bone 2019, 121, 121–133. [Google Scholar] [CrossRef]
- Farr, J.N.; Fraser, D.G.; Wang, H.; Jaehn, K.; Ogrodnik, M.B.; Weivoda, M.M.; Drake, M.T.; Tchkonia, T.; LeBrasseur, N.K.; Kirkland, J.L.; et al. Identification of Senescent Cells in the Bone Microenvironment. J. Bone Miner. Res. 2016, 31, 1920–1929. [Google Scholar] [CrossRef]
- Chen, X.; Wang, L.; Hou, J.; Li, J.; Chen, L.; Xia, J.; Wang, Z.; Xiao, M.; Wang, Y. Study on the Dynamic Biological Characteristics of Human Bone Marrow Mesenchymal Stem Cell Senescence. Stem Cells Int. 2019, 2019, 9271595. [Google Scholar] [CrossRef]
- Gao, X.; Lu, A.; Tang, Y.; Schneppendahl, J.; Liebowitz, A.B.; Scibetta, A.C.; Morris, E.R.; Cheng, H.; Huard, C.; Amra, S.; et al. Influences of Donor and Host Age on Human Muscle-Derived Stem Cell-Mediated Bone Regeneration. Stem Cell Res. Ther. 2018, 9, 316. [Google Scholar] [CrossRef]
- Zhai, W.; Yong, D.; El-jawhari, J.J.; Cuthbert, R.; Mcgonagle, D.; Win Naing, M.; Jones, E. Identification of Senescent Cells in Multipotent Mesenchymal Stromal Cell Cultures: Current Methods and Future Directions. Cytotherapy 2019, 21, 803–819. [Google Scholar] [CrossRef] [PubMed]
- Ponzetti, M.; Rucci, N. Osteoblast Differentiation and Signaling: Established Concepts and Emerging Topics. Int. J. Mol. Sci. 2021, 22, 6651. [Google Scholar] [CrossRef] [PubMed]
- Kawada, M.; Hamajima, S.; Abiko, Y. Osteomodulin Gene Expression in Human Bone Marrow-Derived Mesenchymal Stem Cells into Osteoblastic Differentiation. Int. J. Oral-Med. Sci. 2006, 4, 170–176. [Google Scholar] [CrossRef]
- Lin, W.; Zhu, X.; Gao, L.; Mao, M.; Gao, D.; Huang, Z. Osteomodulin Positively Regulates Osteogenesis through Interaction with BMP2. Cell Death Dis. 2021, 12, 147. [Google Scholar] [CrossRef]
- Rosset, E.M.; Bradshaw, A.D. SPARC/Osteonectin in Mineralized Tissue. Matrix. Biol. 2016, 52–54, 78–87. [Google Scholar] [CrossRef]
- Dvorakova, J.; Wiesnerova, L.; Chocholata, P.; Kulda, V.; Landsmann, L.; Cedikova, M.; Kripnerova, M.; Eberlova, L.; Babuska, V. Human Cells with Osteogenic Potential in Bone Tissue Research. Biomed. Eng. Online 2023, 22, 33. [Google Scholar] [CrossRef]
- Gerhard, E.M.; Wang, W.; Li, C.; Guo, J.; Ozbolat, I.T.; Rahn, K.M.; Armstrong, A.D.; Xia, J.; Qian, G.; Yang, J. Design Strategies and Applications of Nacre-Based Biomaterials. Acta Biomater. 2017, 54, 21–34. [Google Scholar] [CrossRef]
- Zhang, G.; Brion, A.; Willemin, A.-S.; Piet, M.-H.; Moby, V.; Bianchi, A.; Mainard, D.; Galois, L.; Gillet, P.; Rousseau, M. Nacre, a Natural, Multi-Use, and Timely Biomaterial for Bone Graft Substitution. J. Biomed. Mater. Res. Part A 2017, 105, 662–671. [Google Scholar] [CrossRef]
- Willemin, A.-S.; Zhang, G.; Velot, E.; Bianchi, A.; Decot, V.; Rousseau, M.; Gillet, P.; Moby, V. The Effect of Nacre Extract on Cord Blood-Derived Endothelial Progenitor Cells: A Natural Stimulus to Promote Angiogenesis? J. Biomed. Mater. Res. Part A 2019, 107, 1406–1413. [Google Scholar] [CrossRef]
- Silve, C.; Lopez, E.; Vidal, B.; Smith, D.C.; Camprasse, S.; Camprasse, G.; Couly, G. Nacre Initiates Biomineralization by Human Osteoblasts Maintained In Vitro. Calcif. Tissue Int. 1992, 51, 363–369. [Google Scholar] [CrossRef]
- Green, D.W.; Kwon, H.-J.; Jung, H.-S. Osteogenic Potency of Nacre on Human Mesenchymal Stem Cells. Mol. Cells 2015, 38, 267–272. [Google Scholar] [CrossRef]
- Atlan, G.; Balmain, N.; Berland, S.; Vidal, B.; Lopez, É. Reconstruction of Human Maxillary Defects with Nacre Powder: Histological Evidence for Bone Regeneration. Comptes Rendus De L’académie Des Sci. Ser. III Sci. De La Vie 1997, 320, 253–258. [Google Scholar] [CrossRef]
- Atlan, G.; Delattre, O.; Berland, S.; LeFaou, A.; Nabias, G.; Cot, D.; Lopez, E. Interface between Bone and Nacre Implants in Sheep. Biomaterials 1999, 20, 1017–1022. [Google Scholar] [CrossRef]
- Berland, S.; Delattre, O.; Borzeix, S.; Catonné, Y.; Lopez, E. Nacre/Bone Interface Changes in Durable Nacre Endosseous Implants in Sheep. Biomaterials 2005, 26, 2767–2773. [Google Scholar] [CrossRef] [PubMed]
- Leelatian, L.; Chunhabundit, P.; Charoonrut, P.; Asvanund, P. Induction of Osseointegration by Nacre in Pigs. Molecules 2022, 27, 2653. [Google Scholar] [CrossRef]
- Delattre, O.; Catonne, Y.; Berland, S.; Borzeix, S.; Lopez, E. Use of Mother of Pearl as a Bone Substitute—Experimental Study in Sheep. Eur. J. Orthop. Surg. Traumatol. 1997, 7, 143–147. [Google Scholar] [CrossRef]
- Iandolo, D.; Laroche, N.; Nguyen, D.K.; Normand, M.; Met, C.; Zhang, G.; Vico, L.; Mainard, D.; Rousseau, M. Preclinical Safety Study of Nacre Powder in an Intraosseous Sheep Model. BMJ Open Sci. 2022, 6, e100231. [Google Scholar] [CrossRef] [PubMed]
- Lamghari, M.; Almeida, M.J.; Berland, S.; Huet, H.; Laurent, A.; Milet, C.; Lopez, E. Stimulation of Bone Marrow Cells and Bone Formation by Nacre: In Vivo and in Vitro Studies. Bone 1999, 25, 91S–94S. [Google Scholar] [CrossRef]
- Lamghari, M.; Berland, S.; Laurent, A.; Huet, H.; Lopez, E. Bone Reactions to Nacre Injected Percutaneously into the Vertebrae of Sheep. Biomaterials 2001, 22, 555–562. [Google Scholar] [CrossRef]
- Lamghari, M.; Antonietti, P.; Berland, S.; Laurent, A.; Lopez, E. Arthrodesis of Lumbar Spine Transverse Processes Using Nacre in Rabbit. J. Bone Miner. Res. 2001, 16, 2232–2237. [Google Scholar] [CrossRef]
- Flausse, A.; Henrionnet, C.; Dossot, M.; Dumas, D.; Hupont, S.; Pinzano, A.; Mainard, D.; Galois, L.; Magdalou, J.; Lopez, E.; et al. Osteogenic Differentiation of Human Bone Marrow Mesenchymal Stem Cells in Hydrogel Containing Nacre Powder. J. Biomed. Mater. Res. Part A 2013, 101, 3211–3218. [Google Scholar] [CrossRef] [PubMed]
- Pereira Mouriès, L.; Almeida, M.-J.; Milet, C.; Berland, S.; Lopez, E. Bioactivity of Nacre Water-Soluble Organic Matrix from the Bivalve Mollusk Pinctada Maxima in Three Mammalian Cell Types: Fibroblasts, Bone Marrow Stromal Cells and Osteoblasts. Comp. Biochem. Physiol. Part B Biochem. Mol. Biol. 2002, 132, 217–229. [Google Scholar] [CrossRef]
- Almeida, M.J.; Pereira, L.; Milet, C.; Haigle, J.; Barbosa, M.; Lopez, E. Comparative Effects of Nacre Water-Soluble Matrix and Dexamethasone on the Alkaline Phosphatase Activity of MRC-5 Fibroblasts. J. Biomed. Mater. Res. 2001, 57, 306–312. [Google Scholar] [CrossRef]
- Rousseau, M.; Boulzaguet, H.; Biagianti, J.; Duplat, D.; Milet, C.; Lopez, E.; Bédouet, L. Low Molecular Weight Molecules of Oyster Nacre Induce Mineralization of the MC3T3-E1 Cells. J. Biomed. Mater. Res. Part A 2008, 85A, 487–497. [Google Scholar] [CrossRef]
- Bédouet, L.; Rusconi, F.; Rousseau, M.; Duplat, D.; Marie, A.; Dubost, L.; Le Ny, K.; Berland, S.; Péduzzi, J.; Lopez, E. Identification of Low Molecular Weight Molecules as New Components of the Nacre Organic Matrix. Comp. Biochem. Physiol. Part B Biochem. Mol. Biol. 2006, 144, 532–543. [Google Scholar] [CrossRef] [PubMed]
- Lao, Y.; Zhang, X.; Zhou, J.; Su, W.; Chen, R.; Wang, Y.; Zhou, W.; Xu, Z.-F. Characterization and in Vitro Mineralization Function of a Soluble Protein Complex P60 from the Nacre of Pinctada Fucata. Comp. Biochem. Physiol. Part B Biochem. Mol. Biol. 2007, 148, 201–208. [Google Scholar] [CrossRef] [PubMed]
- Zhang, C.; Li, S.; Ma, Z.; Xie, L.; Zhang, R. A Novel Matrix Protein P10 from the Nacre of Pearl Oyster (Pinctada Fucata) and Its Effects on Both CaCO3 Crystal Formation and Mineralogenic Cells. Mar. Biotechnol. 2006, 8, 624–633. [Google Scholar] [CrossRef]
- Daneshmandi, L.; Holt, B.D.; Arnold, A.M.; Laurencin, C.T.; Sydlik, S.A. Ultra-Low Binder Content 3D Printed Calcium Phosphate Graphene Scaffolds as Resorbable, Osteoinductive Matrices That Support Bone Formation in Vivo. Sci. Rep. 2022, 12, 6960. [Google Scholar] [CrossRef]
- Hosseini, F.S.; Nair, L.S.; Laurencin, C.T. Inductive Materials for Regenerative Engineering. J. Dent. Res. 2021, 100, 1011–1019. [Google Scholar] [CrossRef] [PubMed]
- Cushnie, E.K.; Ulery, B.D.; Nelson, S.J.; Deng, M.; Sethuraman, S.; Doty, S.B.; Lo, K.W.H.; Khan, Y.M.; Laurencin, C.T. Simple Signaling Molecules for Inductive Bone Regenerative Engineering. PLoS ONE 2014, 9, e101627. [Google Scholar] [CrossRef]
- Laurencin, C.T.; Nair, L.S. The Quest toward Limb Regeneration: A Regenerative Engineering Approach. Regen. Biomater. 2016, 3, 123–125. [Google Scholar] [CrossRef] [PubMed]
- Ogueri, K.S.; Jafari, T.; Escobar Ivirico, J.L.; Laurencin, C.T. Polymeric Biomaterials for Scaffold-Based Bone Regenerative Engineering. Regen. Eng. Transl. Med. 2019, 5, 128–154. [Google Scholar] [CrossRef]
- Moutahir-belqasmi, F.; Balmain, N.; Lieberrher, M.; Borzeix, S.; Berland, S.; Barthelemy, M.; Peduzzi, J.; Milet, C.; Lopez, E. Effect of Water Soluble Extract of Nacre (Pinctada Maxima) on Alkaline Phosphatase Activity and Bcl-2 Expression in Primary Cultured Osteoblasts from Neonatal Rat Calvaria. J. Mater. Sci. Mater. Med. 2001, 12, 1–6. [Google Scholar] [CrossRef]
- Chaturvedi, R.; Singha, P.K.; Dey, S. Water Soluble Bioactives of Nacre Mediate Antioxidant Activity and Osteoblast Differentiation. PLoS ONE 2013, 8, e84584. [Google Scholar] [CrossRef]
- Yamamoto, H.; Shimomura, N.; Oura, K.; Hasegawa, Y. Nacre Extract from Pearl Oyster Shell Prevents D-Galactose-Induced Brain and Skin Aging. Mar. Biotechnol. 2023, 25, 503–518. [Google Scholar] [CrossRef] [PubMed]
- Julien, A.; Kanagalingam, A.; Martínez-Sarrà, E.; Megret, J.; Luka, M.; Ménager, M.; Relaix, F.; Colnot, C. Direct Contribution of Skeletal Muscle Mesenchymal Progenitors to Bone Repair. Nat. Commun. 2021, 12, 2860. [Google Scholar] [CrossRef] [PubMed]
- Owston, H.; Giannoudis, P.V.; Jones, E. Do Skeletal Muscle MSCs in Humans Contribute to Bone Repair? A Systematic Review. Injury 2016, 47 (Suppl. 6), S3–S15. [Google Scholar] [CrossRef]
- Shah, K.; Majeed, Z.; Jonason, J.; O’Keefe, R.J. The Role of Muscle in Bone Repair: The Cells, Signals, and Tissue Responses to Injury. Curr. Osteoporos. Rep. 2013, 11, 130–135. [Google Scholar] [CrossRef]
- Beane, O.S.; Fonseca, V.C.; Cooper, L.L.; Koren, G.; Darling, E.M. Impact of Aging on the Regenerative Properties of Bone Marrow-, Muscle-, and Adipose-Derived Mesenchymal Stem/Stromal Cells. PLoS ONE 2014, 9, e115963. [Google Scholar] [CrossRef]
- Seebach, C.; Henrich, D.; Tewksbury, R.; Wilhelm, K.; Marzi, I. Number and Proliferative Capacity of Human Mesenchymal Stem Cells Are Modulated Positively in Multiple Trauma Patients and Negatively in Atrophic Nonunions. Calcif. Tissue Int. 2007, 80, 294–300. [Google Scholar] [CrossRef]
- Jones, E.; Schäfer, R. Where Is the Common Ground between Bone Marrow Mesenchymal Stem/Stromal Cells from Different Donors and Species? Stem Cell Res. Ther. 2015, 6, 143. [Google Scholar] [CrossRef] [PubMed]

Disclaimer/Publisher’s Note: The statements, opinions and data contained in all publications are solely those of the individual author(s) and contributor(s) and not of MDPI and/or the editor(s). MDPI and/or the editor(s) disclaim responsibility for any injury to people or property resulting from any ideas, methods, instructions or products referred to in the content. |
© 2024 by the authors. Licensee MDPI, Basel, Switzerland. This article is an open access article distributed under the terms and conditions of the Creative Commons Attribution (CC BY) license (https://creativecommons.org/licenses/by/4.0/).
Share and Cite
Wilson, B.J.; Owston, H.E.; Iqbal, N.; Giannoudis, P.V.; McGonagle, D.; Pandit, H.; Philipose Pampadykandathil, L.; Jones, E.; Ganguly, P. In Vitro Osteogenesis Study of Shell Nacre Cement with Older and Young Donor Bone Marrow Mesenchymal Stem/Stromal Cells. Bioengineering 2024, 11, 143. https://doi.org/10.3390/bioengineering11020143
Wilson BJ, Owston HE, Iqbal N, Giannoudis PV, McGonagle D, Pandit H, Philipose Pampadykandathil L, Jones E, Ganguly P. In Vitro Osteogenesis Study of Shell Nacre Cement with Older and Young Donor Bone Marrow Mesenchymal Stem/Stromal Cells. Bioengineering. 2024; 11(2):143. https://doi.org/10.3390/bioengineering11020143
Chicago/Turabian StyleWilson, Bridget Jeyatha, Heather Elizabeth Owston, Neelam Iqbal, Peter V. Giannoudis, Dennis McGonagle, Hemant Pandit, Lizymol Philipose Pampadykandathil, Elena Jones, and Payal Ganguly. 2024. "In Vitro Osteogenesis Study of Shell Nacre Cement with Older and Young Donor Bone Marrow Mesenchymal Stem/Stromal Cells" Bioengineering 11, no. 2: 143. https://doi.org/10.3390/bioengineering11020143
APA StyleWilson, B. J., Owston, H. E., Iqbal, N., Giannoudis, P. V., McGonagle, D., Pandit, H., Philipose Pampadykandathil, L., Jones, E., & Ganguly, P. (2024). In Vitro Osteogenesis Study of Shell Nacre Cement with Older and Young Donor Bone Marrow Mesenchymal Stem/Stromal Cells. Bioengineering, 11(2), 143. https://doi.org/10.3390/bioengineering11020143

